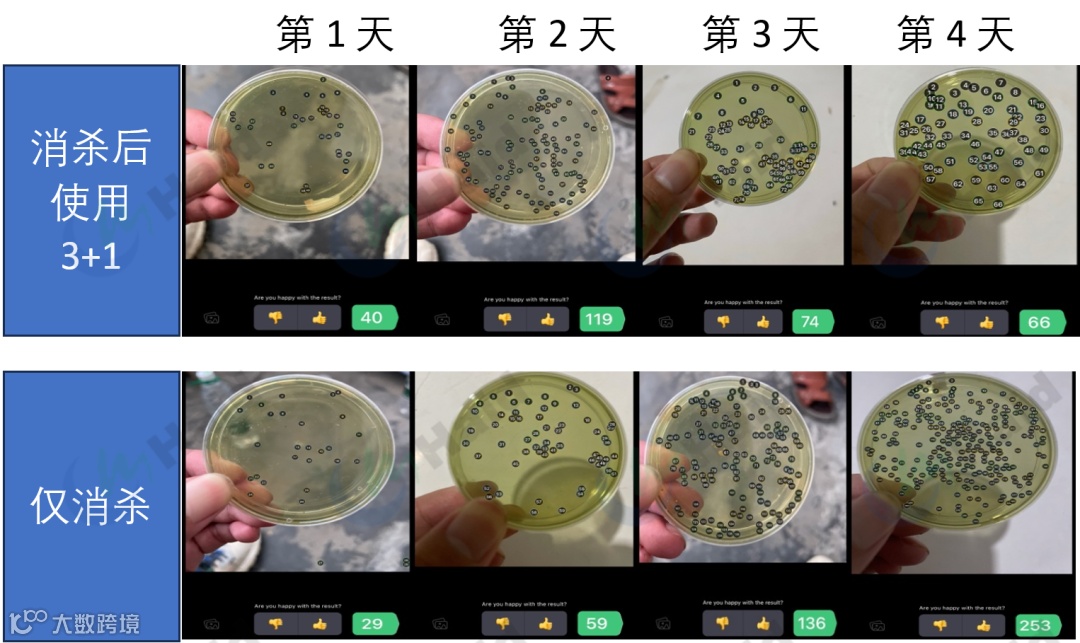

文 | 图 动保事业部 周鹏程
池塘消杀后介入“罗氏3+1”补菌,干预池塘中有害菌的数量,减少池塘发病的概率!
目前大宗鱼市场整体发病仍较为严重,随着气温回升,投喂量也开始逐渐增加,在这种情况下,水质该如何调节?
今年大宗鱼疾病十分严重,几乎90%的养殖池塘都有不同程度的发病,病原体其实还是我们的老熟人——嗜水气单胞菌。嗜水气单胞菌几乎可以感染所有的淡水养殖鱼类,导致鱼类急性出血性败血症,一旦爆发极难治疗,今年华中地区的鱼病大爆发,嗜水气单胞菌也是罪魁祸首之一。

▲今年5月以来大量发病,让人十分心痛!
二、治不如防
本次鱼病来势汹汹,且十分难以根治,往往死鱼数量开始下降,养殖户稍有放松,病害又开始反复,持续1到2个月都在死鱼,不少客户的池塘5月初即开始发病,到6月下旬池塘每天还有数十条死鱼。在这一两个月中,往往使用了不下3套治疗方案,都不作用。
防病于未然才是治疗的最高境界,海大的治疗方案也一直是提倡预防第一,治疗第二。我们在大宗鱼养殖方案中,一直提倡稳定水质,使用罗氏3+1促进水质稳定。
三、罗氏“3+1”防病初探
以往控制环境病原,都是以消杀为主,通过各种消杀产品,消灭有害病菌(往往连益生菌一起消灭);但消杀产品不仅杀灭了有害菌,而且连有益菌也杀死了,往往杀完了菌过几天有害菌又爆发了。
“罗氏3+1”仅仅作为高温期稳水促投的产品组合,不仅能将残饵粪便转化为生物絮团,成为花白鲢的饵料,还能快速提供有益菌,对水体中的有害菌进行有效地抑制。
我们选择两个条件相近的池塘,雨过天晴第一天使用二氧化氯进行消杀。
48小时后,一个使用“罗氏3+1”进行补菌操作,另一个不做后续操作;我们对其水质状况和有害菌数量进行检测。
可以看到:由于发病导致投喂较少,氨氮亚盐都不高,PH波动也都处于稳态。

但在有害菌数量方面:使用了“罗氏3+1”的池塘,有害菌数量在第一天达到顶峰119后,后面开始稳步下降;而未使用“罗氏3+1”补菌的池塘,后续有害菌数量还在稳步增加!
由此可见,通过消杀后及时介入“罗氏3+1”补菌,可以及时干预池塘中有害菌的数量,使益生菌占据有利生态位,从而减少池塘发病的概率!
四、小结
在发病高峰期,建议各位老板晴后第一天使用海消全池泼洒杀灭细菌。
在泼洒48小时后,及时使用“罗氏3+1”进行补菌操作,用益生菌与有害菌进行竞争,从而控制有害菌的数量,同时可以有效稳水,减少鱼的应激,预防减轻病害!

END
本文系海大农牧(微信号:haid002311)原创,未经授权,一律禁止转载!文章投稿、转载授权,欢迎发邮件到:haidnm@haid.com.cn





